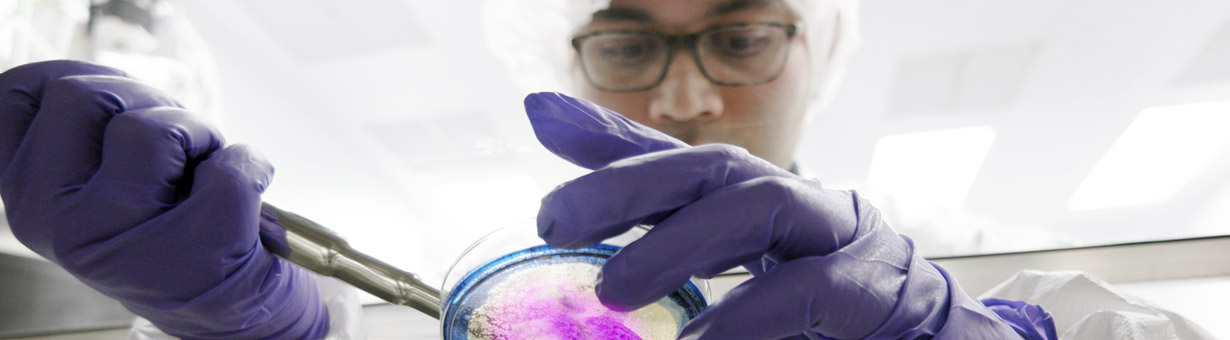

Career Enhancements
Internships & Opportunities
BizBio is dedicated to providing information about opportunities and internships, information sessions, and programs for students interested in consulting. Below are consulting info sessions and internships for graduate students and postdoctoral fellows.
Bain's Summer Associate (SA) program is an ideal opportunity for MBAs or advanced degree candidates to experience the real world of consulting while discovering what a future with Bain would be like.
Flagship Pioneering seeks outstanding scientists, engineers, inventors and budding entrepreneurs who are eager to create first-in-category biotech companies from scratch. Fellows work hand-in-hand with Flagship’s seasoned professionals through our uniquely entrepreneurial scientific exploration process to produce unprecedented impact and value.
IQVIA is a world leader in using data, technology, advanced analytics, and expertise to help customers drive healthcare forward. Together with the companies we serve, we are enabling a more modern and effective healthcare system and creating breakthrough solutions that transform business and patient outcomes.
Academy Leadership Development Program Details:
This program begins with an intensive 12-week training period to prepare its members for client-facing roles with IQVIA’s pharmaceutical clients. During this full-time training, you will hone your data analytics and consulting skillset through a combination of classroom-based lectures, interactive case studies, hands-on working sessions, client role-playing scenarios, and real-time project shadowing/support. As a result, you will develop a strong network consisting of internal IQVIA leaders, subject matter experts, and countless other Academy alums.
Aptagen, LLC is a biotechnology and life-sciences company, and global leader in developing aptamers (synthetic antibody) products and services. These products can be used as research agents, diagnostics, biosensors, and tools for biomarker or drug discovery. Aptamers can also be used for bioindustrial applications and targeted therapeutics.
Aptagen is seeking qualified and highly motivated M.S. Students, College Graduates, and Postdoctoral Fellows who seek training opportunities and professional experience in biotechnology. Applications are accepted year around. Paid stipend and free housing is available for some positions.